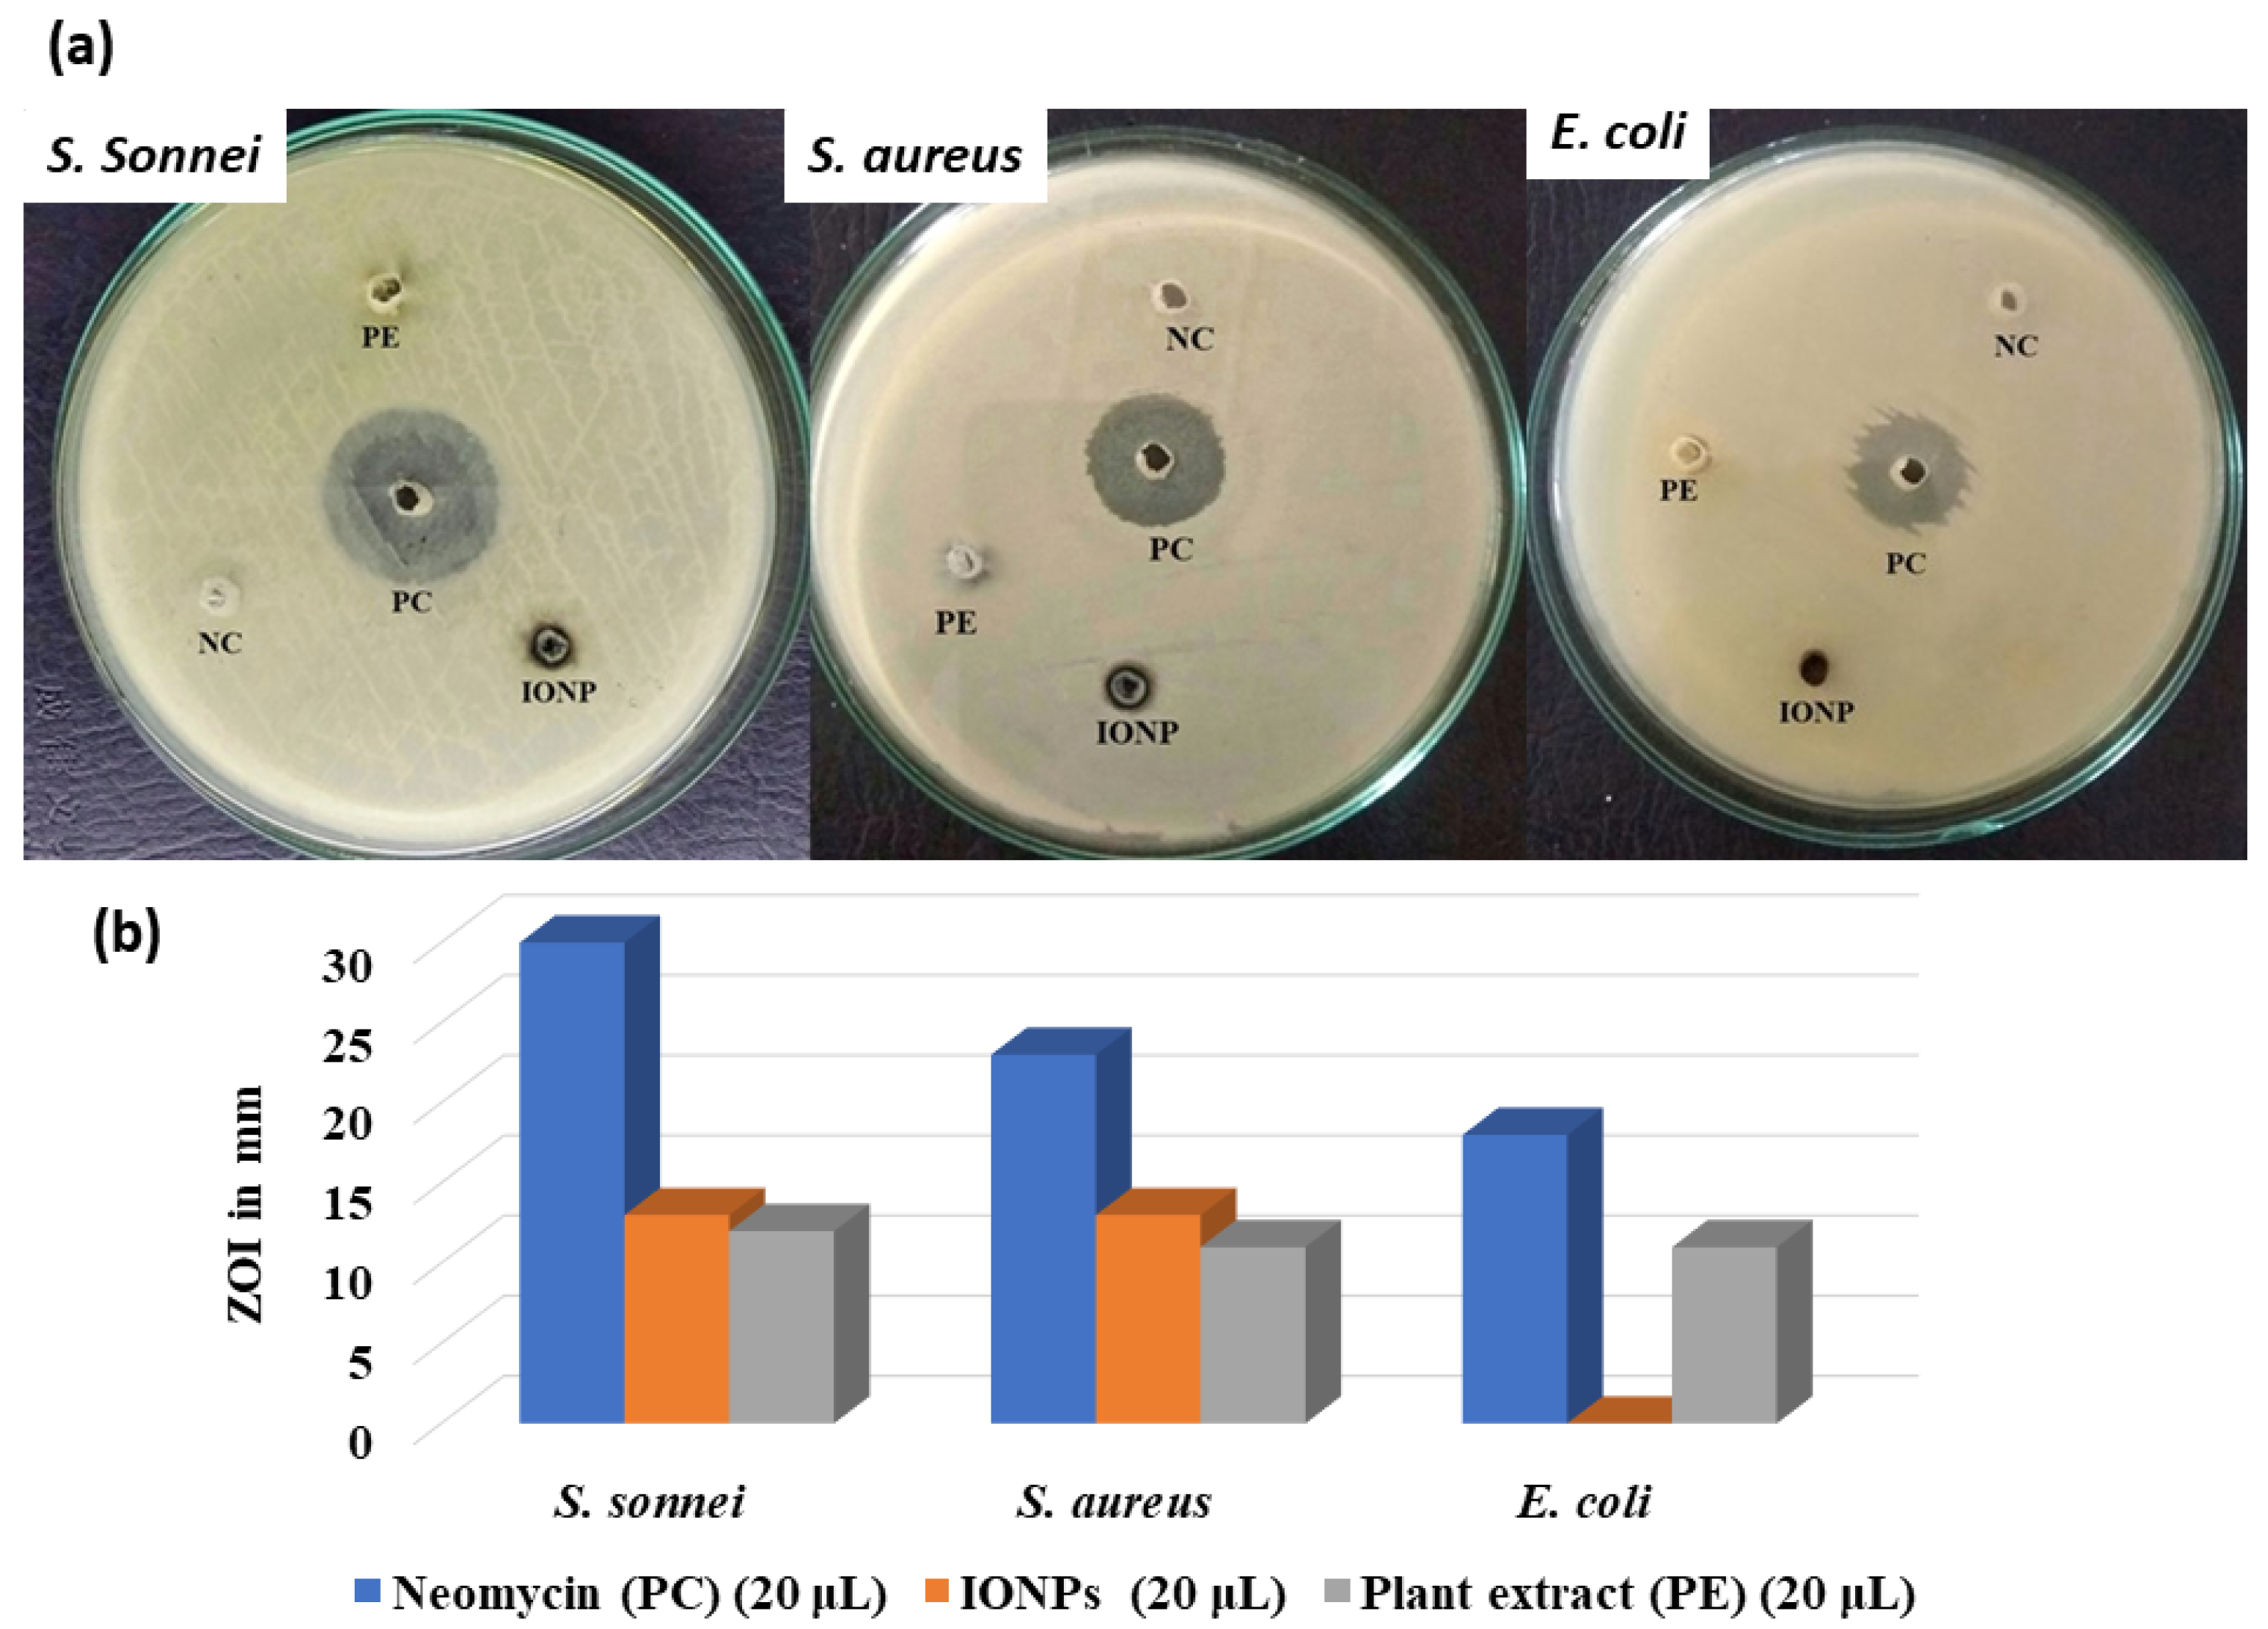

Green Synthesis of Iron Oxide Nanoparticles Using Psidium guajava L. Leaves Extract for Degradation of Organic Dyes and Anti-microbial Applications
Abstract
1. Introduction
2. Results and Discussion
3. Materials and Methods
3.1. Plant Extract Preparation
3.2. Biosynthesis of Iron Oxide Nanoparticles
3.3. Dye Degradation Assay
3.4. Anti-microbial Activity of IONPs
4. Conclusions
Supplementary Materials
Author Contributions
Funding
Data Availability Statement
Acknowledgments
Conflicts of Interest
References
- Narayan, N.; Meiyazhagan, A.; Vajtai, R. Metal Nanoparticles as Green Catalysts. Materials 2019, 12, 3602. [Google Scholar] [CrossRef] [PubMed]
- Naseem, T.; Durrani, T. The Role of Some Important Metal Oxide Nanoparticles for Wastewater and Antibacterial Applications: A Review. Environ. Chem. Ecotoxicol. 2021, 3, 59–75. [Google Scholar] [CrossRef]
- Chapagain, A.; Acharya, D.; Das, A.K.; Chhetri, K.; Oli, H.B.; Yadav, A.P. Alkaloid of Rhynchostylis Retusa as Green Inhibitor for Mild Steel Corrosion in 1 M H2SO4 Solution. Electrochem 2022, 3, 211–224. [Google Scholar] [CrossRef]
- Adhikari, A.; Bhattarai, B.R.; Aryal, A.; Thapa, N.; Kc, P.; Adhikari, A.; Maharjan, S.; Chanda, P.B.; Regmi, B.P.; Parajuli, N. Reprogramming Natural Proteins Using Unnatural Amino Acids. RSC Adv. 2021, 11, 38126–38145. [Google Scholar] [CrossRef] [PubMed]
- Gupta, A.K.; Gupta, M. Cytotoxicity Suppression and Cellular Uptake Enhancement of Surface Modified Magnetic Nanoparticles. Biomaterials 2005, 26, 1565–1573. [Google Scholar] [CrossRef] [PubMed]
- Faraji, A.H.; Wipf, P. Nanoparticles in Cellular Drug Delivery. Bioorg. Med. Chem. 2009, 17, 2950–2962. [Google Scholar] [CrossRef] [PubMed]
- Karlsson, H.L.; Holgersson, Å.; Möller, L. Mechanisms Related to the Genotoxicity of Particles in the Subway and from Other Sources. Chem. Res. Toxicol. 2008, 21, 726–731. [Google Scholar] [CrossRef]
- Wilson, J.; Murray, V.; Kettle, J.N. The July 2005 London Bombings: Environmental Monitoring, Health Risk Assessment and Lessons Identified for Major Incident Response. Occup. Environ. Med. 2009, 66, 642–643. [Google Scholar] [CrossRef]
- Adhikari, A.; Lamichhane, L.; Adhikari, A.; Gyawali, G.; Acharya, D.; Baral, E.R.; Chhetri, K. Green Synthesis of Silver Nanoparticles Using Artemisia Vulgaris Extract and Its Application toward Catalytic and Metal-Sensing Activity. Inorganics 2022, 10, 113. [Google Scholar] [CrossRef]
- Priya; Naveen; Kaur, K.; Sidhu, A.K. Green Synthesis: An Eco-Friendly Route for the Synthesis of Iron Oxide Nanoparticles. Front. Nanotechnol. 2021, 3, 6555062. [Google Scholar]
- Dakappa, S.S.; Adhikari, R.; Timilsina, S.S.; Sajjekhan, S. A Review on the Medicinal Plant Psidium guajava Linn. (Myrtaceae). J. Drug Deliv. Ther. 2013, 3, 2. [Google Scholar] [CrossRef]
- Rahim, N.; Gomes, D.J.; Watanabe, H.; Rahman, S.R.; Chomvarin, C.; Endtz, H.P.; Alam, M. Antibacterial Activity of Psidium guajava Leaf and Bark against Multidrug-Resistant Vibrio Cholerae: Implication for Cholera Control. Jpn J. Infect. Dis. 2010, 63, 271–274. [Google Scholar] [CrossRef] [PubMed]
- Smith, R.M.; Siwatibau, S. Sesquiterpene Hydrocarbons of Fijian Guavas. Phytochemistry 1975, 14, 2013–2015. [Google Scholar] [CrossRef]
- Naseer, S.; Hussain, S.; Naeem, N.; Pervaiz, M.; Rahman, M. The Phytochemistry and Medicinal Value of Psidium guajava (Guava). Clin. Phytosci. 2018, 4, 32. [Google Scholar] [CrossRef]
- Akhavan, O.; Azimirad, R. Photocatalytic Property of Fe2O3 Nanograin Chains Coated by TiO2 Nanolayer in Visible Light Irradiation. Appl. Catal. A Gen. 2009, 369, 77–82. [Google Scholar] [CrossRef]
- Bandara, J.; Klehm, U.; Kiwi, J. Raschig Rings-Fe2O3 Composite Photocatalyst Activate in the Degradation of 4-Chlorophenol and Orange II under Daylight Irradiation. Appl. Catal. B Environ. 2007, 76, 73–81. [Google Scholar] [CrossRef]
- Feng, W.; Nansheng, D.; Helin, H. Degradation Mechanism of Azo Dye C. I. Reactive Red 2 by Iron Powder Reduction and Photooxidation in Aqueous Solutions. Chemosphere 2000, 41, 1233–1238. [Google Scholar] [CrossRef]
- Xu, P.; Zeng, G.M.; Huang, D.L.; Feng, C.L.; Hu, S.; Zhao, M.H.; Lai, C.; Wei, Z.; Huang, C.; Xie, G.X.; et al. Use of Iron Oxide Nanomaterials in Wastewater Treatment: A Review. Sci. Total Environ. 2012, 424, 1–10. [Google Scholar] [CrossRef]
- Jaafar, N.F.; Abdul Jalil, A.; Triwahyono, S.; Muhd Muhid, M.N.; Sapawe, N.; Satar, M.A.H.; Asaari, H. Photodecolorization of Methyl Orange over α-Fe2O3-Supported HY Catalysts: The Effects of Catalyst Preparation and Dealumination. Chem. Eng. J. 2012, 191, 112–122. [Google Scholar] [CrossRef]
- Bakardjieva, S.; Stengl, V.; Subrt, J.; Houskova, V.; Kalenda, P. Photocatalytic Efficiency of Iron Oxides: Degradation of 4-Chlorophenol. J. Phys. Chem. Sol. 2007, 68, 721–724. [Google Scholar] [CrossRef]
- Umar, A.; Akhtar, M.S.; Dar, G.N.; Baskoutas, S. Low-Temperature Synthesis of α-Fe2O3 Hexagonal Nanoparticles for Environmental Remediation and Smart Sensor Applications. Talanta 2013, 116, 1060–1066. [Google Scholar] [CrossRef] [PubMed]
- Guidolin, T.; Possolli, N.M.; Polla, M.B.; Wermuth, T.B.; Franco de Oliveira, T.; Eller, S.; Klegues Montedo, O.R.; Arcaro, S.; Cechinel, M.A.P. Photocatalytic Pathway on the Degradation of Methylene Blue from Aqueous Solutions Using Magnetite Nanoparticles. J. Clean. Prod. 2021, 318, 128556. [Google Scholar] [CrossRef]
- Gudkov, S.V.; Burmistrov, D.E.; Serov, D.A.; Rebezov, M.B.; Semenova, A.A.; Lisitsyn, A.B. Do Iron Oxide Nanoparticles Have Significant Antibacterial Properties? Antibiotics 2021, 10, 884. [Google Scholar] [CrossRef]
- AlMatar, M.; Makky, E.A.; Var, I.; Koksal, F. The Role of Nanoparticles in the Inhibition of Multidrug-Resistant Bacteria and Biofilms. Curr. Drug Deliv. 2018, 15, 470–484. [Google Scholar] [CrossRef] [PubMed]
- Groiss, S.; Selvaraj, R.; Varadavenkatesan, T.; Vinayagam, R. Structural Characterization, Antibacterial and Catalytic Effect of Iron Oxide Nanoparticles Synthesised Using the Leaf Extract of Cynometra Ramiflora. J. Mol. Struct. 2017, 1128, 572–578. [Google Scholar] [CrossRef]
- Kohanski, M.A.; DePristo, M.A.; Collins, J.J. Sublethal Antibiotic Treatment Leads to Multidrug Resistance via Radical-Induced Mutagenesis. Mol. Cell 2010, 37, 311–320. [Google Scholar] [CrossRef] [PubMed]
- Shahwan, T.; Abu Sirriah, S.; Nairat, M.; Boyacı, E.; Eroğlu, A.E.; Scott, T.B.; Hallam, K.R. Green Synthesis of Iron Nanoparticles and Their Application as a Fenton-like Catalyst for the Degradation of Aqueous Cationic and Anionic Dyes. Chem. Eng. J. 2011, 172, 258–266. [Google Scholar] [CrossRef]
- Guittat, L.; Alberti, P.; Rosu, F.; Van Miert, S.; Thetiot, E.; Pieters, L.; Gabelica, V.; De Pauw, E.; Ottaviani, A.; Riou, J.-F.; et al. Interactions of Cryptolepine and Neocryptolepine with Unusual DNA Structures. Biochimie 2003, 85, 535–547. [Google Scholar] [CrossRef]
- Devatha, C.P.; Thalla, A.K.; Katte, S.Y. Green Synthesis of Iron Nanoparticles Using Different Leaf Extracts for Treatment of Domestic Waste Water. J. Clean. Prod. 2016, 139, 1425–1435. [Google Scholar] [CrossRef]
- Da’na, E.; Taha, A.; Afkar, E. Green Synthesis of Iron Nanoparticles by Acacia Nilotica Pods Extract and Its Catalytic, Adsorption, and Antibacterial Activities. Appl. Sci. 2018, 8, 1922. [Google Scholar] [CrossRef]
- Jamzad, M.; Kamari Bidkorpeh, M. Green Synthesis of Iron Oxide Nanoparticles by the Aqueous Extract of Laurus Nobilis L. Leaves and Evaluation of the Antimicrobial Activity. J. Nanostruct. Chem. 2020, 10, 193–201. [Google Scholar] [CrossRef]
- Somchaidee, P.; Tedsree, K. Green Synthesis of High Dispersion and Narrow Size Distribution of Zero-Valent Iron Nanoparticles Using Guava Leaf (Psidium guajava L.) Extract. Adv. Nat. Sci. Nanosci. Nanotechnol. 2018, 9, 035006. [Google Scholar] [CrossRef]
- Bellamy, L.J. The Infra-Red Spectra of Complex Molecules; Springer: Dordrecht, The Netherlands, 1975; ISBN 978-94-011-6017-9. [Google Scholar]
- Sundari, J.J.; Praba, P.; Brightson, Y.; Brightson Arul Jacob, Y.; Vasantha, V.; Shanmugaiah, V. Green Synthesis and Characterization of Zero Valent Iron Nanoparticles from the Leaf Extract of Psidium guajava Plant and Their Antibacterial Activity. Chem. Sci. Rev. Lett. 2017, 2017, 1244–1252. [Google Scholar]
- Khatri, M.; Gupta, A.; Gyawali, K.; Adhikari, A.; Koirala, A.R.; Parajuli, N. Photocatalytic Degradation of Dyes Using Synthesized δ-MnO2 Nanostructures. Chem. Data Collect. 2022, 39, 100854. [Google Scholar] [CrossRef]
- dos Santos, K.C.; da Silva, M.F.G.; Pereira-Filho, E.R.; Fernandes, J.B.; Polikarpov, I.; Forim, M.R. Polymeric Nanoparticles Loaded with the 3,5,3’-Triiodothyroacetic Acid (Triac), a Thyroid Hormone: Factorial Design, Characterization, and Release Kinetics. Nanotechnol. Sci. Appl. 2012, 5, 37–48. [Google Scholar] [CrossRef]
- Meng, X.; Ryu, J.; Kim, B.; Ko, S. Application of Iron Oxide as a PH-Dependent Indicator for Improving the Nutritional Quality. Clin. Nutr. Res. 2016, 5, 172–179. [Google Scholar] [CrossRef]
- Veloso, C.H.; Filippov, L.O.; Filippova, I.V.; Ouvrard, S.; Araujo, A.C. Adsorption of Polymers onto Iron Oxides: Equilibrium Isotherms. J. Mater. Res. Technol. 2020, 9, 779–788. [Google Scholar] [CrossRef]
- Bhuiyan, M.S.H.; Miah, M.Y.; Paul, S.C.; Aka, T.D.; Saha, O.; Rahaman, M.M.; Sharif, M.J.I.; Habiba, O.; Ashaduzzaman, M. Green Synthesis of Iron Oxide Nanoparticle Using Carica Papaya Leaf Extract: Application for Photocatalytic Degradation of Remazol Yellow RR Dye and Antibacterial Activity. Heliyon 2020, 6, e040603. [Google Scholar] [CrossRef]
- Newbury, D.E. Mistakes Encountered during Automatic Peak Identification in Low Beam Energy X-ray Microanalysis. Scanning 2007, 29, 137–151. [Google Scholar] [CrossRef]
- Liu, R.; Zhao, Y.; Huang, R.; Zhao, Y.; Zhou, H. Shape Evolution and Tunable Properties of Monodisperse Magnetite Crystals Synthesized by a Facile Surfactant-Free Hydrothermal Method. Eur. J. Inorg. Chem. 2010, 2010, 4499–4505. [Google Scholar] [CrossRef]
- Unsoy, G.; Yalcin, S.; Khodadust, R.; Gunduz, G.; Gunduz, U. Synthesis Optimization and Characterization of Chitosan-Coated Iron Oxide Nanoparticles Produced for Biomedical Applications. J. Nanopart. Res. 2012, 14, 964. [Google Scholar] [CrossRef]
- Wang, X.; Liu, Y.; Arandiyan, H.; Yang, H.; Bai, L.; Mujtaba, J.; Wang, Q.; Liu, S.; Sun, H. Uniform Fe3O4 Microflowers Hierarchical Structures Assembled with Porous Nanoplates as Superior Anode Materials for Lithium-Ion Batteries. Appl. Surf. Sci. 2016, 389, 240–246. [Google Scholar] [CrossRef]
- Win, T.T.; Khan, S.; Bo, B.; Zada, S.; Fu, P. Green Synthesis and Characterization of Fe3O4 Nanoparticles Using Chlorella-K01 Extract for Potential Enhancement of Plant Growth Stimulating and Antifungal Activity. Sci. Rep. 2021, 11, 21996. [Google Scholar] [CrossRef]
- Gautam, K.P.; Acharya, D.; Bhatta, I.; Subedi, V.; Das, M.; Neupane, S.; Kunwar, J.; Chhetri, K.; Yadav, A.P. Nickel Oxide-Incorporated Polyaniline Nanocomposites as an Efficient Electrode Material for Supercapacitor Application. Inorganics 2022, 10, 86. [Google Scholar] [CrossRef]
- Xiang, H.; Ren, G.; Zhong, Y.; Yang, X.; Xu, D.; Zhang, Z.; Wang, X. Characterization and Synthesis of Fe3O4@C Nanoparticles by In-Situ Solid-Phase Method. Mater. Res. Express 2021, 8, 025016. [Google Scholar] [CrossRef]
- Loh, K.-S.; Lee, Y.H.; Musa, A.; Salmah, A.A.; Zamri, I. Use of Fe3O4 Nanoparticles for Enhancement of Biosensor Response to the Herbicide 2,4-Dichlorophenoxyacetic Acid. Sensors 2008, 8, 5775–5791. [Google Scholar] [CrossRef]
- Ardakani, L.S.; Alimardani, V.; Tamaddon, A.M.; Amani, A.M.; Taghizadeh, S. Green Synthesis of Iron-Based Nanoparticles Using Chlorophytum Comosum Leaf Extract: Methyl Orange Dye Degradation and Antimicrobial Properties. Heliyon 2021, 7, e06159. [Google Scholar] [CrossRef]
- Eroi, N.S.; Ello, A.S.; Diabaté, D.; Koffi, K.R. Kinetic Study of the Removal of Methyl Orange Dye by Coupling WO3/H2O2. J. Chem. 2022, 2022, e8633545. [Google Scholar] [CrossRef]
- Nguyen, C.H.; Fu, C.-C.; Juang, R.-S. Degradation of Methylene Blue and Methyl Orange by Palladium-Doped TiO2 Photocatalysis for Water Reuse: Efficiency and Degradation Pathways. J. Clean. Prod. 2018, 202, 413–427. [Google Scholar] [CrossRef]
- Muthukumar, H.; Matheswaran, M. Amaranthus Spinosus Leaf Extract Mediated FeO Nanoparticles: Physicochemical Traits, Photocatalytic and Antioxidant Activity. ACS Sustain. Chem. Eng. 2015, 3, 3149–3156. [Google Scholar] [CrossRef]
- Das, S.; Diyali, S.; Vinothini, G.; Perumalsamy, B.; Balakrishnan, G.; Ramasamy, T.; Dharumadurai, D.; Biswas, B. Synthesis, Morphological Analysis, Antibacterial Activity of Iron Oxide Nanoparticles and the Cytotoxic Effect on Lung Cancer Cell Line. Heliyon 2020, 6, e04953. [Google Scholar] [CrossRef] [PubMed]
- Ismail, R.A.; Sulaiman, G.M.; Abdulrahman, S.A.; Marzoog, T.R. Antibacterial Activity of Magnetic Iron Oxide Nanoparticles Synthesized by Laser Ablation in Liquid. Mater. Sci. Eng. C 2015, 53, 286–297. [Google Scholar] [CrossRef] [PubMed]
- Rufus, A.; Sreeju, N.; Philip, D. Synthesis of Biogenic Hematite (α-Fe2O3) Nanoparticles for Antibacterial and Nanofluid Applications. RSC Adv. 2016, 6, 94206–94217. [Google Scholar] [CrossRef]
- Seddighi, N.S.; Salari, S.; Izadi, A.R. Evaluation of Antifungal Effect of Iron-oxide Nanoparticles against Different Candida Species. IET Nanobiotechnol. 2017, 11, 883. [Google Scholar] [CrossRef]
- Caldeirão, A.C.M.; Araujo, H.C.; Tomasella, C.M.; Sampaio, C.; dos Santos Oliveira, M.J.; Ramage, G.; Pessan, J.P.; Monteiro, D.R. Effects of Antifungal Carriers Based on Chitosan-Coated Iron Oxide Nanoparticles on Microcosm Biofilms. Antibiotics 2021, 10, 588. [Google Scholar] [CrossRef]
- Yamamoto, Y.; Imai, N.; Mashima, R.; Konaka, R.; Inoue, M.; Dunlap, W.C. Singlet Oxygen from Irradiated Titanium Dioxide and Zinc Oxide. In Singlet Oxygen, UV-A, and Ozone; Academic Press: Cambridge, MA, USA, 2000; Volume 319, pp. 29–37. [Google Scholar]
- Bibi, I.; Nazar, N.; Ata, S.; Sultan, M.; Ali, A.; Abbas, A.; Jilani, K.; Kamal, S.; Sarim, F.M.; Khan, M.I.; et al. Green Synthesis of Iron Oxide Nanoparticles Using Pomegranate Seeds Extract and Photocatalytic Activity Evaluation for the Degradation of Textile Dye. J. Mater. Res. Technol. 2019, 8, 6115–6124. [Google Scholar] [CrossRef]
- Chen, C.-Y. Photocatalytic Degradation of Azo Dye Reactive Orange 16 by TiO2. Water Air Soil Pollut. 2009, 202, 335–342. [Google Scholar] [CrossRef]
- Khadayat, K.; Sherpa, D.D.; Malla, K.P.; Shrestha, S.; Rana, N.; Marasini, B.P.; Khanal, S.; Rayamajhee, B.; Bhattarai, B.R.; Parajuli, N. Molecular Identification and Antimicrobial Potential of Streptomyces Species from Nepalese Soil. Int. J. Microbiol. 2020, 2020, e8817467. [Google Scholar] [CrossRef]

Publisher’s Note: MDPI stays neutral with regard to jurisdictional claims in published maps and institutional affiliations. |
© 2022 by the authors. Licensee MDPI, Basel, Switzerland. This article is an open access article distributed under the terms and conditions of the Creative Commons Attribution (CC BY) license (https://creativecommons.org/licenses/by/4.0/).
Share and Cite
Adhikari, A.; Chhetri, K.; Acharya, D.; Pant, B.; Adhikari, A. Green Synthesis of Iron Oxide Nanoparticles Using Psidium guajava L. Leaves Extract for Degradation of Organic Dyes and Anti-microbial Applications. Catalysts 2022, 12, 1188. https://doi.org/10.3390/catal12101188
Adhikari A, Chhetri K, Acharya D, Pant B, Adhikari A. Green Synthesis of Iron Oxide Nanoparticles Using Psidium guajava L. Leaves Extract for Degradation of Organic Dyes and Anti-microbial Applications. Catalysts. 2022; 12(10):1188. https://doi.org/10.3390/catal12101188
Chicago/Turabian StyleAdhikari, Anup, Kisan Chhetri, Debendra Acharya, Bishweshwar Pant, and Achyut Adhikari. 2022. "Green Synthesis of Iron Oxide Nanoparticles Using Psidium guajava L. Leaves Extract for Degradation of Organic Dyes and Anti-microbial Applications" Catalysts 12, no. 10: 1188. https://doi.org/10.3390/catal12101188
APA StyleAdhikari, A., Chhetri, K., Acharya, D., Pant, B., & Adhikari, A. (2022). Green Synthesis of Iron Oxide Nanoparticles Using Psidium guajava L. Leaves Extract for Degradation of Organic Dyes and Anti-microbial Applications. Catalysts, 12(10), 1188. https://doi.org/10.3390/catal12101188









